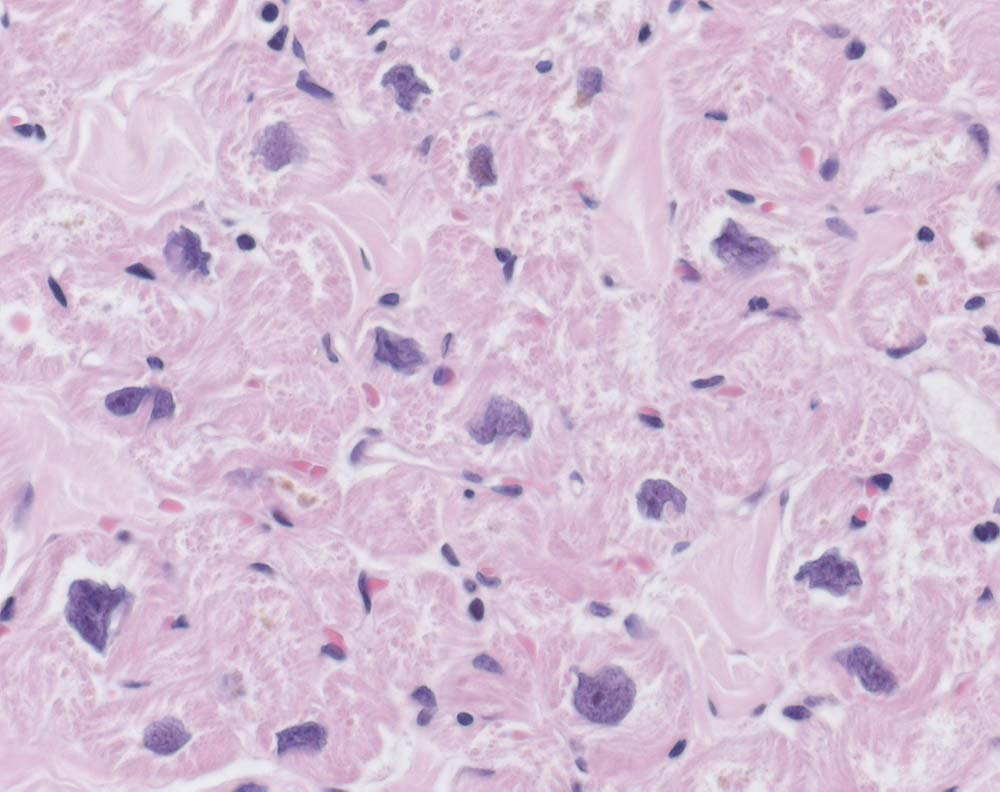
Diagnose

L'œsophage hypercontractile ou œsophage marteau-piqueur, anciennement appelé œsophage casse-noisette, est une affection caractérisée par des contractions excessivement fortes de l'œsophage. Les symptômes peuvent inclure des difficultés à avaler, des régurgitations, des brûlures d'estomac et des douleurs thoraciques. Dans de rares cas, cette affection peut entraîner des complications telles que l’achalasie.
La cause de cette affection est inconnue. Parmi les facteurs de risque figurent l’obésité et le reflux gastro-œsophagien (RGO). Bien que les contractions de l’œsophage soient excessivement fortes, elles restent coordonnées. Le diagnostic repose sur une manométrie œsophagienne, qui met en évidence intégrale contractile distale supérieure à 8 000 mmHg·s·cm ou des pressions excédant 220 mmHg. Il s’agit d’un trouble de la motilité œsophagienne, au même titre que l'achalasie et le spasme œsophagien diffus.
Les options de traitement peuvent inclure des inhibiteurs de la pompe à protons, des inhibiteurs calciques, des nitrates, du butylbromure d'hyoscine, des antidépresseurs, une dilatation de l'œsophage ou une intervention chirurgicale. Cependant, les preuves soutenant ces traitements restent faibles,. Souvent, la maladie se résout d'elle-même sans nécessiter de traitement spécifique.
L'œsophage marteau-piqueur est une affection rare. Elle touche principalement les personnes de plus de 60 ans. Les hommes et les femmes sont affectés de manière égale. Cette maladie a été décrite pour la première fois dans les années 1970. Le terme « œsophage en casse-noix » fait référence aux pressions élevées, comparables à celles générées par un casse-noix mécanique.
Références
- Portail de la médecine